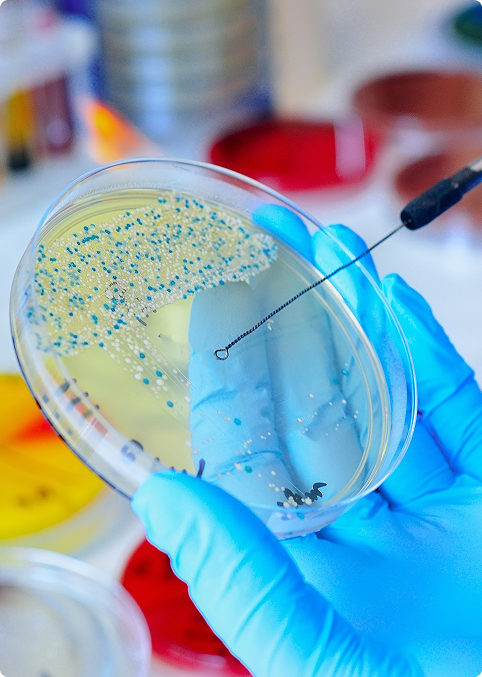

Bioindustrial
Somos la línea de análisis Industriales del Grupo SYNLAB. Buscamos fortalecer los procesos de marcas excepcionales realizando análisis microbiológicos y fisicoquímicos a productos alimenticios, farmacéuticos, aseo y cuidado personal, cosméticos, concentrados animales entre otros. Contamos con una experiencia de más de 30 años, logrando tener una amplia cobertura del territorio nacional respaldado por SYNLAB y un equipo de asesores y expertos en conocimiento técnico en microbiología y fisicoquímico permitiendo:
 Atender la industria a nivel nacional, entregando resultados confiables y oportunos
Atender la industria a nivel nacional, entregando resultados confiables y oportunos
 Estar totalmente alineados con los retos de la industria para prevenir y disminuir los riesgos por calidad e inocuidad de sus productos y procesos productivos
Estar totalmente alineados con los retos de la industria para prevenir y disminuir los riesgos por calidad e inocuidad de sus productos y procesos productivos
 Contribuir al crecimiento de nuestros clientes, quienes logran cumplir la normatividad legal, entregar al consumo productos confiables, generar rentabilidad y fortalecer la reputación de sus marcas
Contribuir al crecimiento de nuestros clientes, quienes logran cumplir la normatividad legal, entregar al consumo productos confiables, generar rentabilidad y fortalecer la reputación de sus marcas


 Sedes y horarios
Sedes y horarios